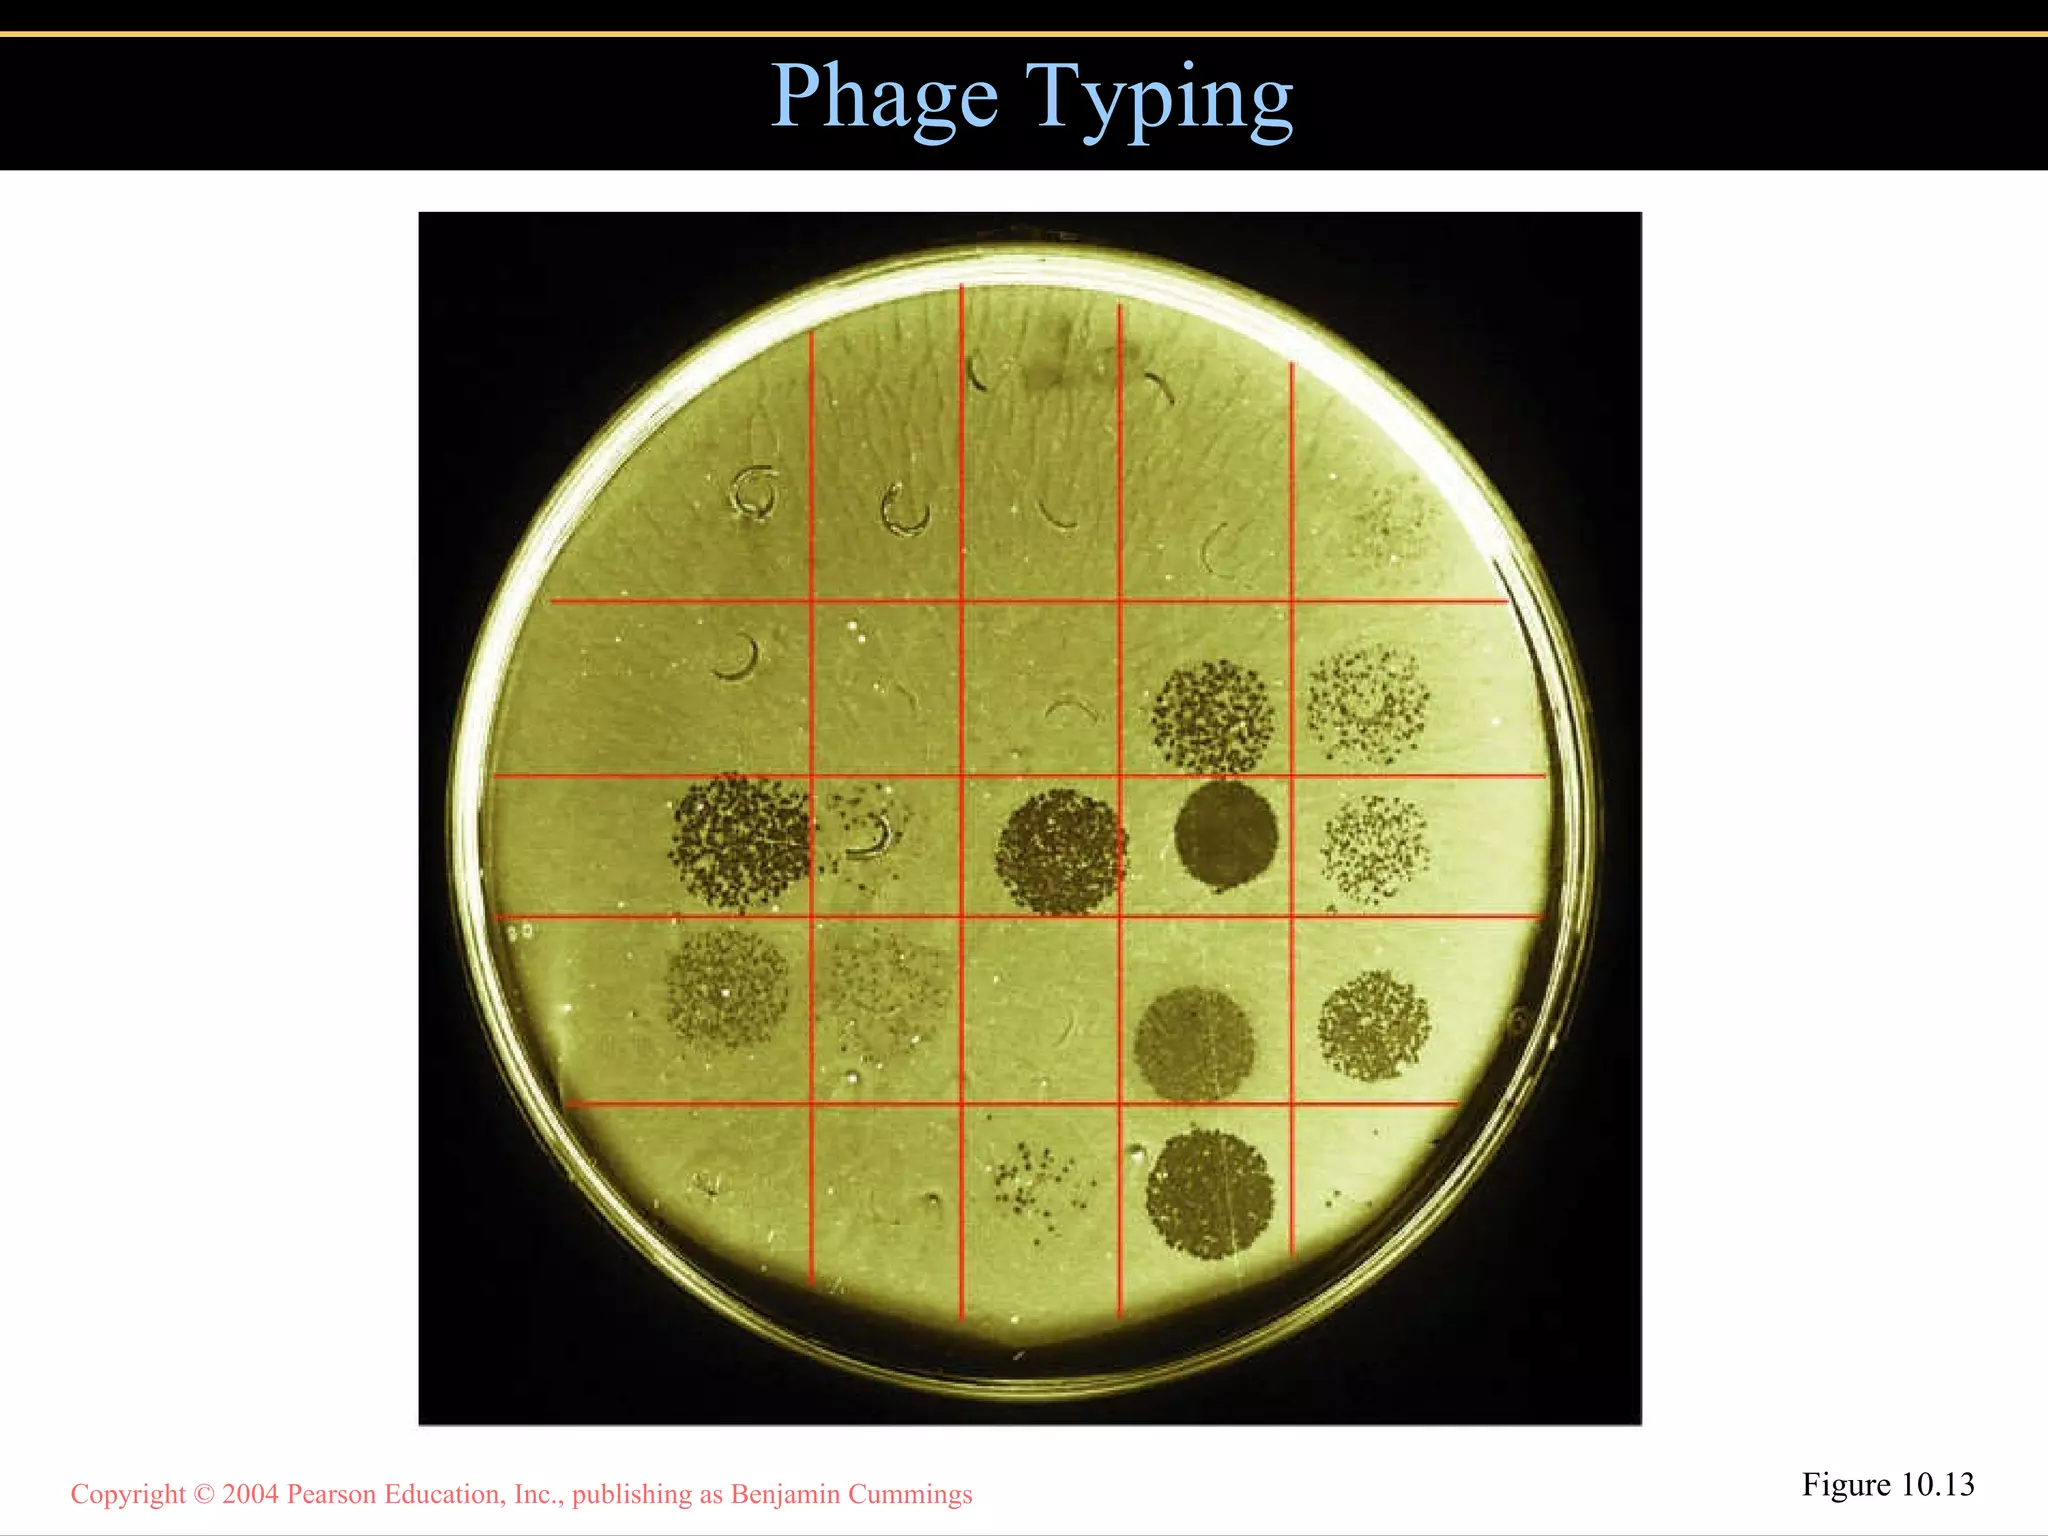
Phage Typing Figure 10.13

Embed presentation
Downloaded 15 times















This document discusses various methods for classifying and identifying microorganisms, including serology techniques like slide agglutination and ELISA that combine antiserum with unknown bacteria, Western blot, and phage typing. It also covers genetic methods such as analyzing DNA base composition, DNA fingerprinting using restriction enzymes, rRNA sequencing, PCR, nucleic acid hybridization using DNA probes and chips, and phylogenetic techniques like dichotomous keys, cladograms, and analyzing differences in electrical conductivity and fluorescence between species.